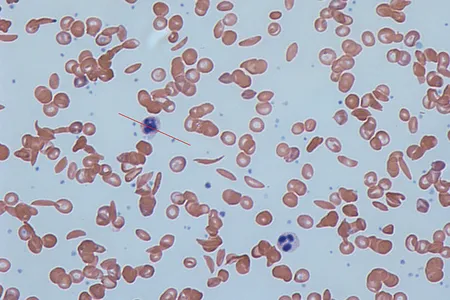

Gifts of Remembrance at the Wall
Near the base of the Vietnam Veterans Memorial, comrades and loved ones leave their poignant tokens of remembrance
25 Years of Looking for the Unexpected
Over the past quarter-century, the magazine has published more than 2,000 major articles
Smithsonian Perspectives
The talent and commitment of our volunteers add immeasurably to the well-being of the Smithsonian
The Floods That Carved the West
In a geological catastrophe, a lake exploded through an Ice Age dam, and its waters swept across the Pacific Northwest; signs of its passage visible
If You Can’t Bear to Part With It, Open a New Museum
Because the chances are, if you love your Mario Lanza albums or your old skate key, there are others who feel the same way
“Do You Swear That You Will Well and Truly Try…?”
Trial by jury has had some ups and downs, but it beats what led up to it—trial by combat, and ordeal by fire, water or poison
Howard Hughes’ H-1 Carried Him “All the Way”
A silver speedster from the 1930s evokes the golden age of flight, a pair of world-class speed records and the early triumphs of Howard Hughes’ life
One Man’s Private Cache Pays Off For The Rest of Us
From the muddy yard of a private collector to the dresser drawers of a dealer, Mitchell Wolfson ransacks the world for his finds
Ruth? He Is Still In The Spotlight, Still Going Strong
A century after his birth, four decades after his death, the amazing Babe maintains a powerful grip on America’s imagination
It’s a New Battle Every Day In The War on Whiskers
Razors have come a long way in 7,000 years, but preparation and a steady hand remain the survival skills each time steel meets skin
Around the Mall & Beyond
At the site of a new Smithsonian museum, a team of archaeologists dug up traces of a 19th-century neighborhood
Smithsonian Perspectives
The electronic transformation that is under way at the Smithsonian will fulfill a central promise of democracy
Frederick Douglass Always Knew He Was Meant to Be Free
Taking to the podium throughout his life,the former slave fought with tireless eloquenceto “secure the Blessings of Liberty” for all
Mrs. Malaprop’s Mangled Prose Set a President
Grande dame of an 18th-century comedy, she has been an aspiration to all who read boners, gaffes and mutilations perpetrated upon the English language
The Battle of Lake Erie
We were floundering in the War of 1812 when young Captain Perry delivered the winning motto, “Don’t Give Up The Ship”
Smithsonian Perspectives
The modern museum trend toward interpretive exhibitions presents both challenges and opportunities
Believe It or Not, Rip Was Almost as Odd as His Items
Incredible! Incomparable! Robert L. Ripley, who won fame and fortune by celebrating the outlandish, was himself a prime example
Page 292 of 292